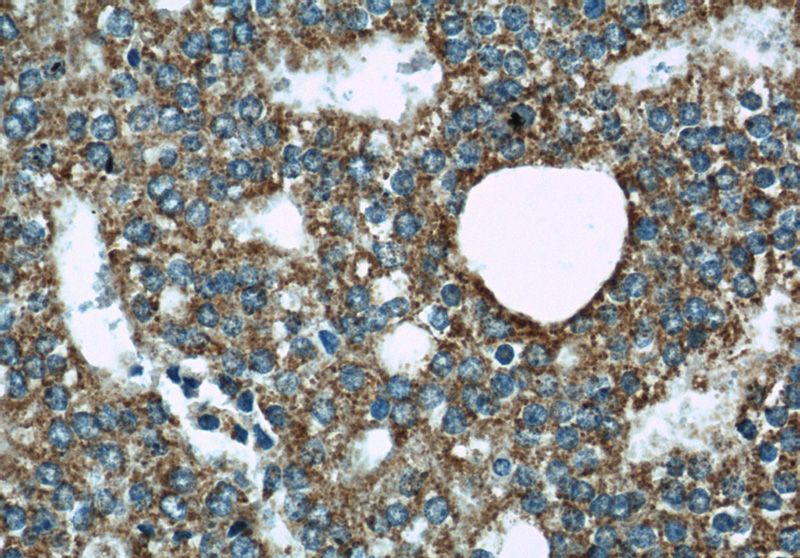
Immunohistochemical of paraffin-embedded human prostate cancer using Catalog No:116971(WSB1 antibody) at dilution of 1:50 (under 40x lens)

-
Product Name
WSB1 antibody
- Documents
-
Description
WSB1 Rabbit Polyclonal antibody. Positive WB detected in SGC-7901 cells, A549 cells, COLO 320 cells. Positive IF detected in HepG2 cells. Positive IHC detected in human prostate cancer tissue, human breast cancer tissue. Observed molecular weight by Western-blot: 56 kDa
-
Tested applications
ELISA, WB, IF, IHC
-
Species reactivity
Human; other species not tested.
-
Alternative names
SWIP1 antibody; WSB 1 antibody; WSB1 antibody
-
Isotype
Rabbit IgG
-
Preparation
This antibody was obtained by immunization of WSB1 recombinant protein (Accession Number: NM_015626). Purification method: Antigen affinity purified.
-
Clonality
Polyclonal
-
Formulation
PBS with 0.1% sodium azide and 50% glycerol pH 7.3.
-
Storage instructions
Store at -20℃. DO NOT ALIQUOT
-
Applications
Recommended Dilution:
WB: 1:500-1:5000
IHC: 1:20-1:200
IF: 1:10-1:100
-
Validations

SGC-7901 cells were subjected to SDS PAGE followed by western blot with Catalog No:116971(WSB1 antibody) at dilution of 1:1000
Immunohistochemical of paraffin-embedded human prostate cancer using Catalog No:116971(WSB1 antibody) at dilution of 1:50 (under 40x lens)

Immunofluorescent analysis of HepG2 cells, using WSB1 antibody Catalog No:116971 at 1:25 dilution and Rhodamine-labeled goat anti-rabbit IgG (red).
-
Background
WSB1 (or SWIP1) gene encodes WD repeat and SocS box-containing protein 1, a member of the WD-protein subfamily. It contains several WD-repeats spanning most of the protein and an SocS box in the C-terminus. Alternatively spliced transcript variants encoding 3 distinct isoforms have been found for this gene. WSB1 serves as a probable substrate-recognition component of a SCF-like ECS (Elongin-Cullin-SocS-box protein) E3 ubiquitin ligase complex which mediates the ubiquitination and subsequent proteasomal degradation of target proteins. Ubiquitination and degradation of homeodomain-interacting protein kinase 2 by WSB1 has been reported (PMID: 15965468), initiated by the interaction of the two components (PMID: 18093972). WSB1 is also a part of an E3 ubiquitin ligase for the thyroid-hormone-activating type 2 iodothyronine deiodinase (D2) (PMID: 15965468).
-
References
- Kim JJ, Lee SB, Jang J. WSB1 promotes tumor metastasis by inducing pVHL degradation. Genes & development. 29(21):2244-57. 2015.
Related Products / Services
Please note: All products are "FOR RESEARCH USE ONLY AND ARE NOT INTENDED FOR DIAGNOSTIC OR THERAPEUTIC USE"
